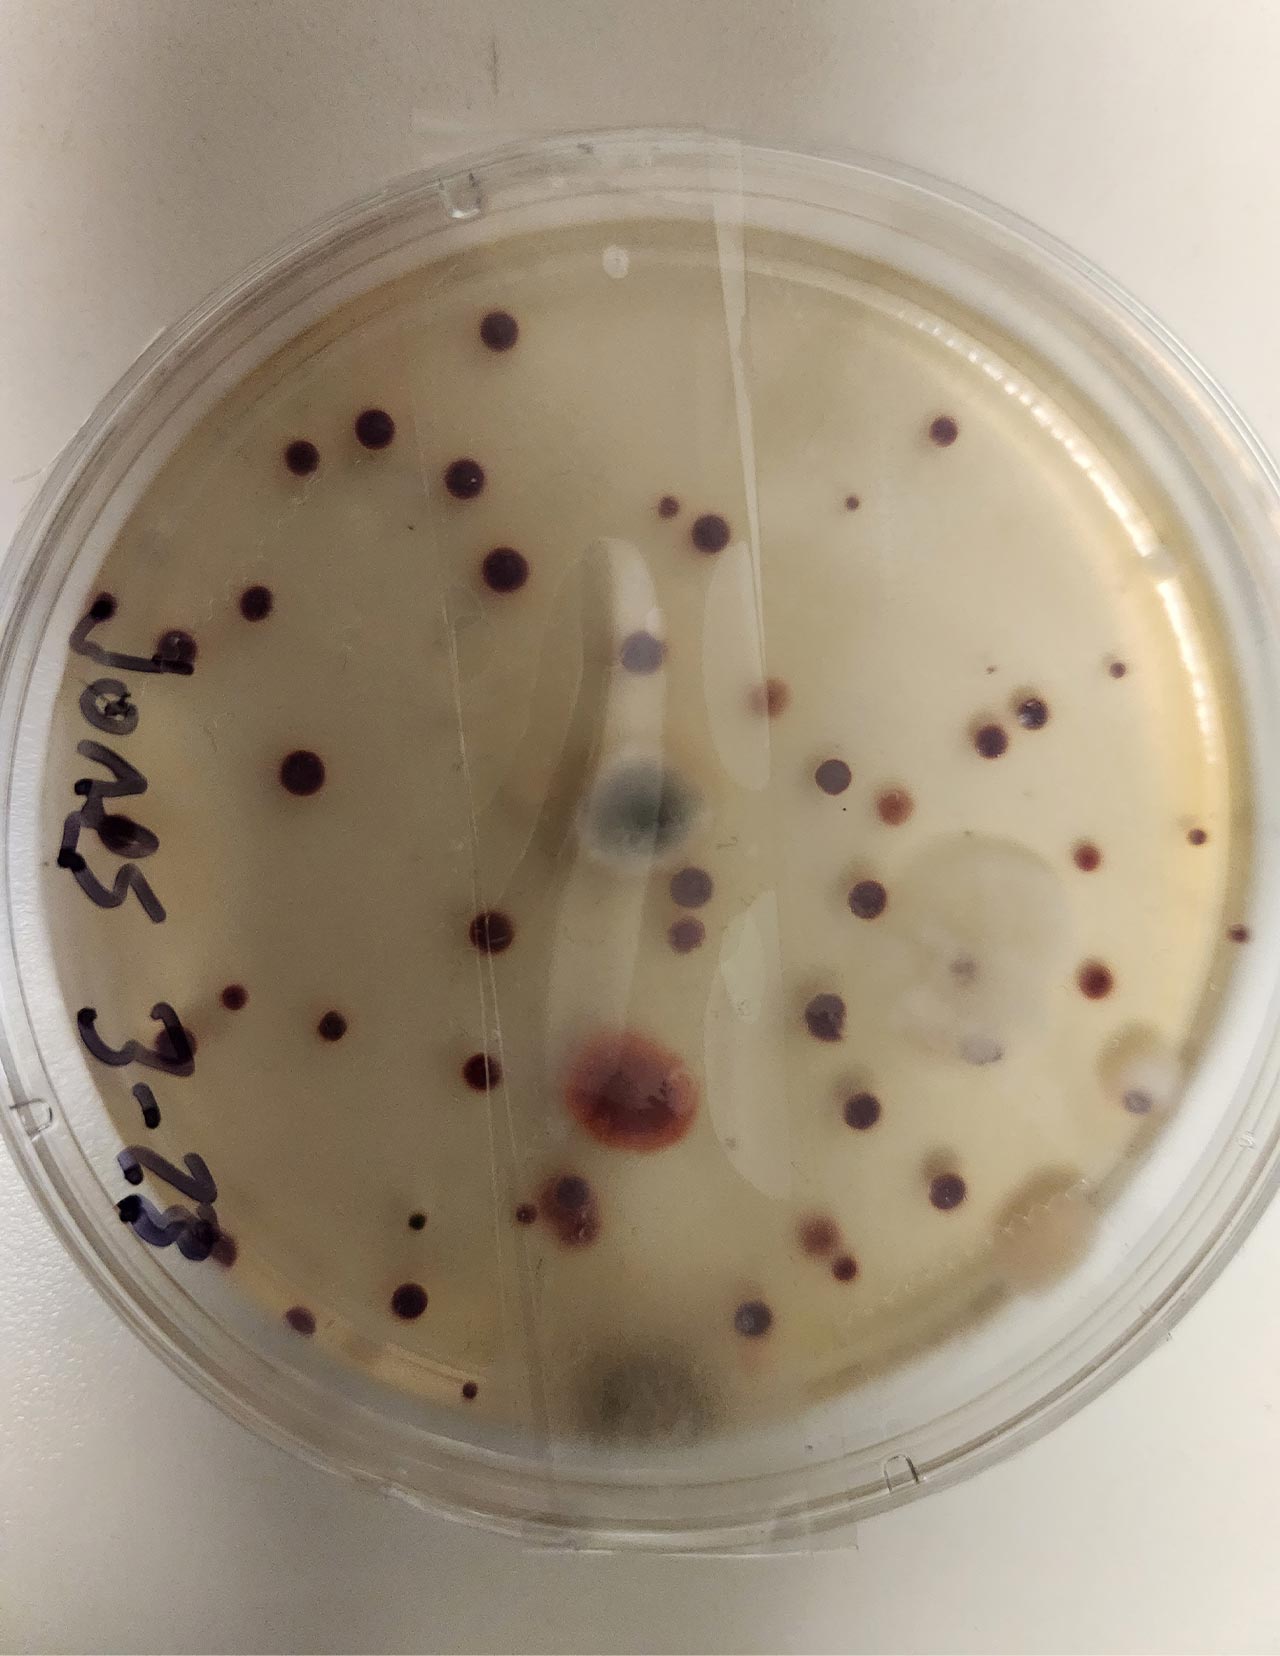
Professional mold inspector testing a Santa Barbara home
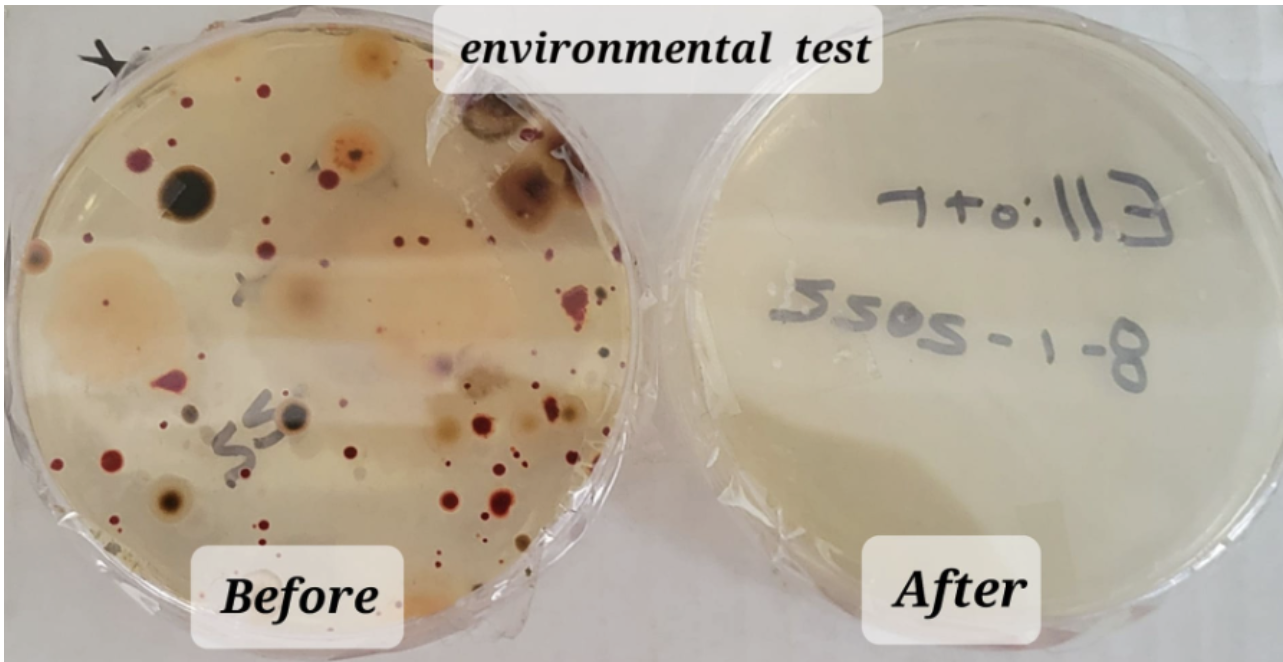
ACAS certification badge

Mold Testing in Santa Barbara and Ventura County
Certified Inspections. Accredited Lab Results. Unbiased Findings.
If you're dealing with unexplained health symptoms, water damage, persistent musty odors, or need documentation for a property transaction, Advanced Clean Air Solutions can help. We provide professional mold testing throughout Santa Barbara and Ventura Counties using certified inspectors and accredited third-party laboratories — so you receive clear, reliable results you can trust.
Our Mold Testing Process
Our process is straightforward and designed to minimize disruption to your home or business. After the on-site inspection and sample collection, results are available in as little as one business day.
Visual Inspection
A certified inspector conducts a detailed walkthrough of your property, focusing on your areas of concern and identifying visible mold growth, signs of moisture intrusion, and other high-risk locations — such as bathrooms and kitchens — where mold commonly develops.
Sample Collection
We collect air samples using specialized, professional-grade equipment and always include an outdoor control sample to establish the normal baseline for comparison. By comparing indoor air to outdoor levels, we can determine whether mold spores are elevated inside the property. If indoor mold spore levels are significantly higher than the outdoor baseline, it may indicate a mold issue. Depending on what we observe during the inspection and the concerns you share, we may also recommend surface sampling. The number and location of samples are determined by the property's conditions and your specific concerns. Our pricing is based on the number of samples collected, so smaller homes or situations with fewer areas of concern may require fewer samples, while larger properties or more complex situations may require additional testing.
Laboratory Analysis
All samples are analyzed by an independent, accredited laboratory. The lab identifies mold types (genus level), quantifies spore concentrations, and compares indoor readings to outdoor baseline levels. The analysis also includes measurements such as particulate matter and pollen, providing a comprehensive assessment of your indoor air quality.
Report and Review
You receive a copy of the laboratory report along with our written summary explaining the findings in clear, easy-to-understand terms. We then review everything with you in a follow-up virtual meeting to answer your questions and help you understand what the results mean for your home or business.
Ready to Schedule Your Mold Inspection?
Call us for a free estimate — we'll walk you through the process, answer your questions, and provide transparent pricing based on your property and concerns.
Mold Test Results:
What Happens After Your Inspection
A mold test is only useful if you understand what to do with the results. After your inspection, we review the findings with you in a follow-up virtual meeting, explaining the data in plain language and discussing practical, cost-effective next steps.
If elevated mold levels are found, we may recommend a Moisture Source Assessment, which helps identify where water is entering the structure so the root cause can be addressed. If additional work is needed, we can also connect you with trusted local contractors.
Because we do not perform remediation ourselves, our role is simply to provide objective information so you can make informed decisions about your property.
Virtual Results Review Meeting
We walk you through your lab report and inspection findings in plain language — no jargon, no upselling.
Moisture Source Assessment
If elevated mold is detected, this add-on helps pinpoint the water intrusion source so the root cause can be properly addressed.
Trusted Contractor Referrals
If remediation is needed, we can connect you with vetted local contractors. We have no financial stake in the recommendation.
Clearance Testing
After remediation, we verify that mold levels have returned to safe ranges with independent post-remediation clearance testing.

Indoor Air Quality & Your Health
Health Effects of Mold Exposure
Mold is not just a property issue — it can also affect your health. Long-term exposure to elevated mold spore levels may contribute to a range of symptoms, particularly for children, seniors, and individuals with asthma, allergies, or weakened immune systems.
Common symptoms associated with poor indoor air quality may include:
If someone in your home or workplace is experiencing these symptoms without a clear explanation, professional mold testing is a simple, non-invasive way to determine whether indoor mold may be contributing to the problem.

Signs You May Have a Mold Problem
Mold is not always visible. In Santa Barbara and Ventura County, coastal humidity and older building construction make hidden mold especially common.
What's Included in Your Mold Test Report
Our reports go beyond the laboratory results. They are written so homeowners, buyers, landlords, and business owners can clearly understand the findings — not just environmental specialists. Each report explains the mold types identified, spore concentration levels, indoor-to-outdoor comparisons, and any areas of concern, along with clear recommendations.
While many companies simply hand you a lab report, we interpret the data and help you understand what it means for your property.
We use accredited laboratories and precise sampling methods so your results are accurate and defensible, whether you need them for a real estate transaction, an insurance claim, or a conversation with your doctor.
Every report includes



Where and Why Mold Grows
Mold needs moisture and warmth. In Santa Barbara and Ventura Counties, the coastal climate combined with aging building stock in areas like Montecito, Goleta, Ojai, and Ventura creates conditions where hidden mold problems are more common than most homeowners expect.

Bathrooms, Kitchens & Laundry Rooms
High humidity from daily use with limited ventilation creates persistent moisture conditions.
Leaks, Plumbing Failures & Storm Intrusion
Water damage — even minor or slow leaks — creates ideal conditions for mold to develop behind walls and under floors.
Foundation Moisture & Poor Drainage
Common in older coastal properties where grading, drainage, and waterproofing may be inadequate.
Condensation on Windows, Pipes & Walls
Cold exterior surfaces collect moisture from warm interior air, especially in winter months.
Poor Ventilation in Attics, Crawl Spaces & HVAC
Stagnant, humid air in enclosed spaces is one of the most common causes of hidden mold growth.
Insulation Gaps
Warm air condensing on cooler surfaces behind walls and ceilings goes undetected for months or years.

Why Choose Advanced Clean Air Solutions
We Test Only. We Never Remediate. 100% Unbiased Results.






We Test Only, Never Remediate
We focus solely on mold testing, giving you honest, unbiased results. You get clear information to make informed decisions — with complete independence and no pressure to buy additional services.
Fast Results When You Need Them
We strive to schedule your testing quickly, sometimes as soon as the next day. Choose express results in 2–3 business days, or standard processing in 5–7 business days.
Easy-to-Understand Reports
Our reports present the findings in a clear, visual format with specific, actionable guidance. During a follow-up call, we walk you through the results and outline targeted, cost-effective next steps.
Certified & Experienced Inspectors
Our inspectors are professionally certified and trained specifically for California's coastal environments — with deep knowledge of local construction, humidity patterns, and common mold triggers in Santa Barbara homes.
Testing for Any Property
We test homes, businesses, rental units, and commercial spaces for mold, airborne contaminants, and indoor air quality issues — identifying hidden risks and protecting everyone's health.
Commitment to the Environment
We are committed to operating as a low-impact company. Our team drives electric vehicles, minimizes waste on every job, and recommends environmentally responsible solutions whenever possible.
Mold Testing FAQs
We serve Santa Barbara and Ventura Counties, including Santa Barbara, Montecito, Goleta, Isla Vista, Carpinteria, Solvang, Lompoc, Santa Maria, Ventura, Oxnard, Camarillo, Thousand Oaks, Ojai, Moorpark, and surrounding communities.
Our laboratory analysis identifies a full range of mold types commonly found in Southern California, including Stachybotrys (black mold), Cladosporium, Aspergillus, Penicillium, and Chaetomium, among others.
We also assess airborne particulate matter, pollen, and key indoor air quality indicators, including humidity and moisture conditions that can increase the risk of mold growth.
Yes. All samples are analyzed by an independent, accredited third-party laboratory. We do not use in-house testing, so your results are objective and scientifically verified. Lab reports are suitable for real estate, insurance, and medical purposes.
Professional mold inspections in Santa Barbara typically range from $499 to $900, depending on the size of the property and the scope of testing required. Our inspector can discuss the appropriate level of testing during the visit, and we're happy to provide an estimate over the phone based on your situation. Call (805) 232-7491 or request a free estimate online.
No. We are a testing-only company. Because we never perform remediation, our findings carry no conflict of interest. If remediation is needed, we can refer you to vetted local contractors.
Areas We Serve
We proudly provide mold and indoor air quality testing throughout Santa Barbara and Ventura Counties, including:
Santa Barbara County
Santa Barbara, Montecito, Summerland, Carpinteria, Goleta, Isla Vista, Gaviota, Santa Ynez, Solvang, Los Olivos, Buellton, Lompoc, Vandenberg AFB, Orcutt, Santa Maria
Ventura County
Ventura, Camarillo, Oxnard, Thousand Oaks, Westlake Village, Simi Valley, Moorpark, Ojai, Oak View
Take the First Step Toward
Cleaner, Safer Air
Protect your home and the health of your loved ones with professional mold testing and indoor air quality solutions.
Serving Santa Barbara and Ventura Counties
Get In Touch
At Advanced Clean Air Solutions, we are committed to providing you with clear, actionable, and eco-friendly solutions for a healthier home or workplace.
Our Commitment to You:
- Clear Communication: Transparent collaboration throughout the entire process.
- Easy-to-Understand Reports: Straightforward insights on mold presence and concentration.
- Tailored Recommendations: Solutions customized to your needs—cost-effective and eco-friendly.
- Guided Understanding: We walk you through every report so you fully understand the findings.
Copyright @ 2026 - All rights reserved
Advanced Clean Air Solutions, LLC
351 Paseo Nuevo 2nd Floor #1033
SANTA BARBARA, CA 93101

